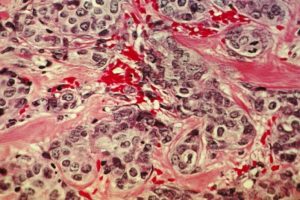

El Gobierno balear y los consejos insulares han acusado al Estado de no aportar soluciones inmediatas a la crisis de acogida de los menores migrantes no acompañados. Después de una reunión en la Delegación del Gobierno, tanto la consejera de Familias y Asuntos Sociales como el presidente del consejo de Mallorca se han mostrado decepcionados con la falta de respuesta del Gobierno central a una situación que "sobrepasa" sus capacidades.
El líder insular ha anunciado que Mallorca no acogerá menores migrantes que lleguen a otros puntos de España, alegando que no pueden asumir esa responsabilidad si no son capaces de atenderlos en condiciones.
Los representantes del Gobierno balear y de la institución insular han criticado que desde el Ejecutivo central solo se planteen soluciones a medio y largo plazo para afrontar una situación de "desborde. Consideran que tienen un problema urgente que se está aplazando, y han cuestionado que todo se confíe al reparto solidario de menores migrantes.
Situación Crítica en Mallorca
En Mallorca, el Instituto Mallorquín de Asuntos Sociales (IMAS) atiende actualmente a 310 menores no acompañados, más de la mitad de los niños y adolescentes atendidos. En lo que va de año, se han producido 202 llegadas, superando las 180 registradas durante todo 2023. El Consejo de Mallorca ha agotado sus recursos disponibles y considera imprescindible que el Gobierno central asuma su responsabilidad para evitar un colapso inminente.
Entre las principales medidas reclamadas por el Consejo de Mallorca al Gobierno central destacan la declaración del estado de emergencia en la isla para agilizar los trámites administrativos, la convocatoria urgente de la Conferencia de Presidentes Autonómicos para tratar la crisis, la implementación de una política migratoria integral por parte del Ejecutivo central y el reconocimiento formal de la ruta migratoria que afecta a Mallorca.
Respuesta del Gobierno Central y Debates sobre el Modelo de Acogida
El secretario de Estado de Juventud e Infancia ha defendido que la prioridad del Gobierno es, primero, trabajar y determinar el modelo de acogida en base a la modificación del artículo 35 de la ley de extranjería, que tendría que fijar las bases para el reparto solidario de menores migrantes entre comunidades. Ha insistido en la necesidad de establecer los umbrales de capacidad de las comunidades autónomas para ver en qué momento el Estado tiene que actuar y cuándo se tienen que hacer los repartos.
Por otro lado, el delegado del Gobierno ha explicado que, a raíz de las demandas de los consejos insulares, el Ministerio de Defensa está estudiando la posibilidad de ceder espacios que puedan ser utilizados para la atención y la acogida de menores. Sin embargo, la consejera de Familias y Asuntos Sociales ha defendido que los espacios de acogida tienen que ser espacios residenciales, como los que se utilizan para atender a otros menores.
En resumen, la crisis de acogida de menores migrantes no acompañados en Mallorca ha llegado a un punto crítico, con las autoridades insulares manifestando su frustración por la falta de respuesta del Gobierno central y la negativa a acoger a más menores que lleguen a otros puntos de España. El Ejecutivo central, por su parte, se centra en definir un modelo de acogida y reparto solidario, mientras que las autoridades locales reclaman medidas urgentes para hacer frente a una situación que consideran "desbordante".